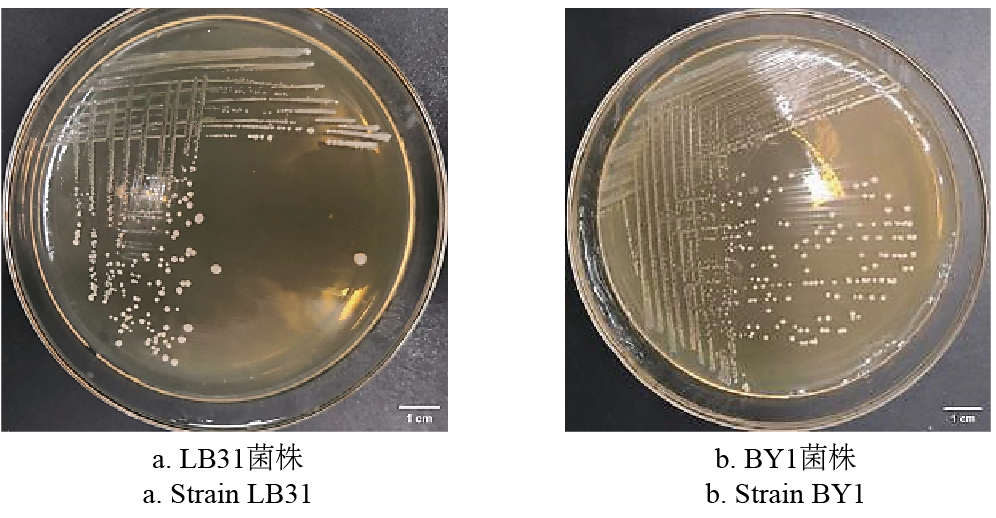

【beat365在线官网入口 王新谱/文 张昱/图】近日,beat365在线官网入口顾欣教授团队在《农业工程学报》发表了题为《复合型乳酸菌剂与厌氧发酵预处理对牛粪好氧堆肥的影响》的研究论文。该研究表明,在牛粪堆肥中添加质量分数3.0%的复合乳酸菌剂,经4天厌氧发酵预处理后再开展好氧堆肥,可显著降低堆肥原料及产物的pH值,有效减少养分流失,不仅为乳酸菌的堆肥应用提供了菌种资源,更为厌氧-好氧组合工艺优化堆肥效果、降低养分损耗奠定了理论依据和技术支撑。

研究团队从新鲜牛粪中分离筛选出2株目标菌株,分别为食淀粉乳杆菌(Lactobacillus amylovorus)LB31和类肠膜魏斯氏菌(Weissella paramesenteroides)BY1;并通过试验确定两菌株制备复合菌剂的最佳活菌数比例为7:3。
为验证复合菌剂与厌氧发酵预处理的协同作用,研究设置4个处理组及1个空白对照组(CK,无任何添加),具体分组如下:T1组为物料添加复合菌剂后,经厌氧发酵4 d后再进行好氧发酵;T2组为添加复合菌剂后直接通气好氧发酵;T3组为添加硫酸通气后直接好氧发酵;T4组为同时添加硫酸和复合菌剂后直接好氧发酵,混合均匀后进行好氧堆肥。
试验结果显示,经厌氧发酵预处理的物料pH值从初始7.67降至7.38,其中T1较CK降低了4.07%。堆肥结束后,与CK相比,T1处理的碳、氮损失最少,分别降低27.53%和37.50%,速效磷、速效钾质量分数分别增加14.68%和10.95%,pH值降低0.46。这一结果进一步印证了核心结论,即3.0%复合乳酸菌剂搭配4天厌氧发酵预处理的组合方式,能有效优化牛粪好氧堆肥过程。
图1 菌落形态
Figure 1 Colony morphology

图2 堆肥化学与养分特性
Figure 2 Composting chemical and nutrient characteristics
beat365在线官网入口硕士生张昱为第一作者,顾欣教授为通讯作者。研究工作得到了国家重点研发计划项目(2024YFD1700500)和宁夏回族自治区重点研发计划重点项目(2018BBF02004)的资助。
